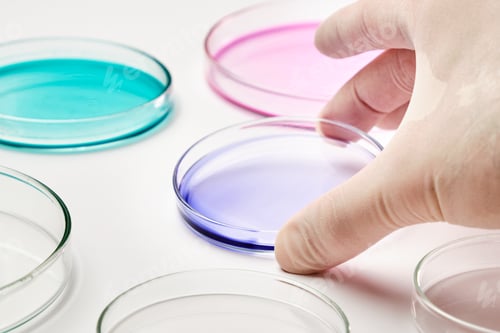
Visualização: Feche um cientista ou biólogo com luvas de borracha segurando uma placa de Petri com mídia colorida para

Bolo de brownie de feliz aniversário com amendoim, caramelo salgado e velas coloridas acesas na violeta
Por RimidoloveDownloads ilimitados a partir de US$ 16,50/mês
- 26+ milhões ativos e modelos premium
- Pilha completa de IA: vídeo, imagem e geração de áudio
- Licença comercial vitalícia
- Cancelamento fácil
Já tem uma conta? Inicie a sessão
Atributos